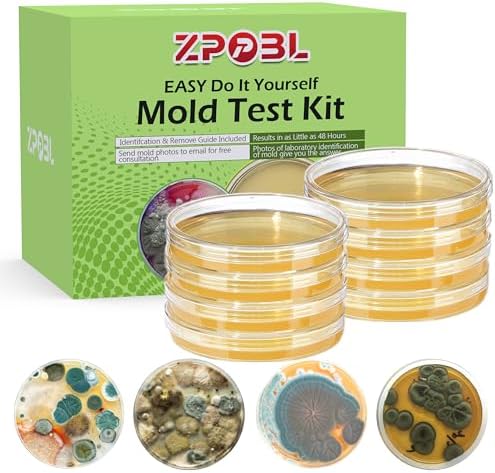
Mold Test Kit for Home, 8 Detection Tests for HVAC, Surfaces & Indoor Air Quality, DIY Black Home Mold Detector Testing kit, Identification Guide & Free Lab Analysis Included

Product description
MENGLISI WILL KEEP YOU CONFIDENT, COMFORTABLE AND BEAUTIFUL!

Originating from people's pursuit of a better life, design concepts are still being used to design jewelry with the development of the times
Jewelry symbolizes the purity of love, and MENGLISI adds sweet embellishments to these fashionable earrings
Classic Eternal Transmission
Heart shaped earrings for the elegant woman.

BRILLIANT AAA+ HIGH QUALITY CUBIC ZIRCONIA

Individual collocation, let your modelling have individual character more.

Why choose our earring sets?


Trustworthy
Our products are free of nickel and other ingredients, gentle to the skin, ideal for sensitive skinTrustworthy

316 Surgical Steel
We use 316 gauge surgical steel in all of our products to ensure hypoallergenic properties and AAAAA cubic zirconia for a sparkling shine.

Made by famous designers
All our products are made by branded designers to show off your taste.

Exquisite gift box packaging
The perfect gift for a loved one
MENGLISI Commitment